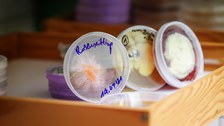

Study Biotechnology and Applied Ecology
Table of contents
Content of the program
This program is designed for future international experts on biotechnological research, production, environmental protection and conservation.
In order to meet the demands of adaptibility and flexibility of the job market, great importancde is attached to the acquisition of fundamental knowledge in the fields of practical microbiology and biotechnology, as well as ecology and ecosystems.
You can choose between the fields of study „Biotechnology“ and „Biodiversity and Nature Conservation“.
Short Facts (Overview)
| Cooperative program with | University of Applied Sciences Zittau/Görlitz |
|---|---|
| Degree | Master of Science |
| Duration | 4 semesters (2 years) |
| Language of tuition |
Mainly German with some courses held in English |
| Admission requirements | Bachelor (at least 6 semesters!) in natural sciences |
| Courses at | Zittau |
|
Fees |
Most students only pay a Semester fee of "Studentenwerk Dresden" (including a semester ticket). In some cases (2nd master degree, long-time studies etc.), study fees can be compulsory. |
| Accreditation | Diploma of Accreditation |
Further important information and conditions regarding the study program, such as the study requirements, the deadlines and the link to the application, can be found in our central Study information system / Studieninformationssystem (SINS). to the program in SINS

© IHI Zittau

© IHI Zittau/Tettenborn

© Amac Garbe

© Amac Garbe

© Amac Garbe

© Amac Garbe

© Amac Garbe

© Amac Garbe

© Amac Garbe
Advisory
Any questions regarding the program and application? We are happy to help you!
 © Michael Kretzschmar, TUD
© Michael Kretzschmar, TUD
Study advisory
NameMs Uta Scheunig Dipl.-Verwaltungswirtin (FH)
Send encrypted email via the SecureMail portal (for TUD external users only).
Visiting address:
Technische Universität Dresden
IHI Zittau, Haus 1, Raum 3.05
Markt 23
02763 Zittau
Office hours:
nach Vereinbarung